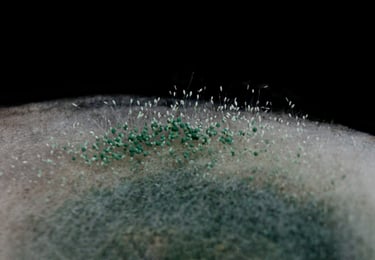

Activitats 2025

Voces de la Naturaleza.
Editorial Carbrame (Capítulo 8).
"Hongos un mundo desconocido".
16 de maig de 2025
Boek Visual
La aventura del Saber
12 de juny de 2025
Link a programa de RTVE:
Boek Visual. La aventura del saber (RTVE)
Projecció per pantalla de 45 fotografies amb el text d'Eduardo Barbero i acompanyades de música.
Activitat divulgativa:
Xerrada divulgativa sobre el món microbià recolzada amb imatges artístiques i vídeo i amb la participació de diversos microbiòlegs.
Divulgació en art i ciència
Fototalks
Organitzat per QGAT
2 d'octubre de 2024